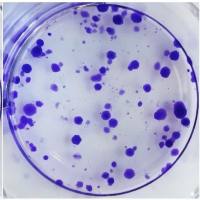
细胞克隆形成

万千商家帮你免费找货
0 人在求购买到急需产品
- 详细信息
- 技术资料
- 服务名称:
细胞培养
- 提供商:
XSL
细胞培养:从体内组织取出细胞,在体外培养使其生长繁殖并维持其结构和功能的一种培养技术。
细胞培养的意义
1.是细胞生物学研究中最基础、最基本的一项技术,可以用来进行药物筛选、疫苗生产、抗体制备等。
2. 可以模拟复杂的生命活动机制 in vitro(体外)-in vivo(体内)。最主要是大部分实验无法把活体作为实验对象,因此需要首先在细胞水平进行研究,再从体内进行验证。
3. 可以通过细胞培养获得大量实验细胞,进而研究实验细胞的信号转导、物质及能量代谢以及细胞的增殖凋亡等。
常见细胞培养类型
1. 原代细胞培养:
从生物体组织、器官中分离得到的原代细胞,通过机械方法、酶、螯合剂(如EDTA)来处理分散成单细胞,置于培养基中进行培养,注意原代培养的贴壁依赖性细胞需要使用促进贴壁的包被培养皿(如使用多聚赖氨酸),从而帮助细胞贴壁,促进细胞的生长和增殖。。
2. 贴壁细胞培养:
贴壁培养主要适用于贴壁依赖性的细胞,细胞贴附于培养皿的表面生长,当生长铺满平面时会发生接触抑制,此时就需要对细胞进行传代处理。传代方式也是采用酶消化法,可根据具体需要,选择是否使用多聚赖氨酸铺皿来促进细胞贴壁生长。
3. 悬浮细胞培养:
悬浮培养主要适用于非贴壁依赖性的细胞,细胞或者细胞的聚集体悬浮于培养液中,悬浮培养是一种大规模细胞培养的理想方式。悬浮培养需要保持良好的分散状态,因此需要再振荡的条件下培养,形成分散良好的悬浮培养物。当细胞培养至一定密度时需进行传代,传代时需去除较大的细胞聚集体和残渣物。
4. 干细胞的培养:
干细胞具有自我更新和自我维持的能力,可以无限次地进行增殖分裂,是一类尚未充分分化多潜能的细胞,在一定条件下,可以分化成多种功能细胞。根据干细胞的类型选择贴壁培养或悬浮培养的方式,通常干细胞生长于铺有辅助附着的细胞外基质的成分(如明胶、基质胶或胶原蛋白等)或是MEF饲养层的培养皿上,除了这类传统的二维培养技术,还可以使用三维的培养技术来模拟生物机体内环境,可根据不同的细胞类型来进行培养条件的优化和分析。
实验完成周期及交付标准
1. 实验周期:一般细胞培养时间为2-5天,特殊细胞培养根据细胞说明书而定。原代细胞需要购买动物提取组织进行分离和消化,一般时间为1-2周。
2. 交付标准:细胞图片、实验报告(试剂、耗材、实验步骤)
需确认的信息
1. 需要培养细胞的具体名称?
2. 客户是否提供细胞还是我方代购?
3. 细胞培养只是为本实验获得标本,我们需要具体对细胞进行哪些具体生物学功能检测?如增殖、凋亡、迁移、侵袭等。
细胞培养的意义
1.是细胞生物学研究中最基础、最基本的一项技术,可以用来进行药物筛选、疫苗生产、抗体制备等。
2. 可以模拟复杂的生命活动机制 in vitro(体外)-in vivo(体内)。最主要是大部分实验无法把活体作为实验对象,因此需要首先在细胞水平进行研究,再从体内进行验证。
3. 可以通过细胞培养获得大量实验细胞,进而研究实验细胞的信号转导、物质及能量代谢以及细胞的增殖凋亡等。
常见细胞培养类型
1. 原代细胞培养:
从生物体组织、器官中分离得到的原代细胞,通过机械方法、酶、螯合剂(如EDTA)来处理分散成单细胞,置于培养基中进行培养,注意原代培养的贴壁依赖性细胞需要使用促进贴壁的包被培养皿(如使用多聚赖氨酸),从而帮助细胞贴壁,促进细胞的生长和增殖。。
2. 贴壁细胞培养:
贴壁培养主要适用于贴壁依赖性的细胞,细胞贴附于培养皿的表面生长,当生长铺满平面时会发生接触抑制,此时就需要对细胞进行传代处理。传代方式也是采用酶消化法,可根据具体需要,选择是否使用多聚赖氨酸铺皿来促进细胞贴壁生长。
3. 悬浮细胞培养:
悬浮培养主要适用于非贴壁依赖性的细胞,细胞或者细胞的聚集体悬浮于培养液中,悬浮培养是一种大规模细胞培养的理想方式。悬浮培养需要保持良好的分散状态,因此需要再振荡的条件下培养,形成分散良好的悬浮培养物。当细胞培养至一定密度时需进行传代,传代时需去除较大的细胞聚集体和残渣物。
4. 干细胞的培养:
干细胞具有自我更新和自我维持的能力,可以无限次地进行增殖分裂,是一类尚未充分分化多潜能的细胞,在一定条件下,可以分化成多种功能细胞。根据干细胞的类型选择贴壁培养或悬浮培养的方式,通常干细胞生长于铺有辅助附着的细胞外基质的成分(如明胶、基质胶或胶原蛋白等)或是MEF饲养层的培养皿上,除了这类传统的二维培养技术,还可以使用三维的培养技术来模拟生物机体内环境,可根据不同的细胞类型来进行培养条件的优化和分析。
实验完成周期及交付标准
1. 实验周期:一般细胞培养时间为2-5天,特殊细胞培养根据细胞说明书而定。原代细胞需要购买动物提取组织进行分离和消化,一般时间为1-2周。
2. 交付标准:细胞图片、实验报告(试剂、耗材、实验步骤)
需确认的信息
1. 需要培养细胞的具体名称?
2. 客户是否提供细胞还是我方代购?
3. 细胞培养只是为本实验获得标本,我们需要具体对细胞进行哪些具体生物学功能检测?如增殖、凋亡、迁移、侵袭等。
风险提示:丁香通仅作为第三方平台,为商家信息发布提供平台空间。用户咨询产品时请注意保护个人信息及财产安全,合理判断,谨慎选购商品,商家和用户对交易行为负责。对于医疗器械类产品,请先查证核实企业经营资质和医疗器械产品注册证情况。
技术资料暂无技术资料 索取技术资料
细胞培养
询价